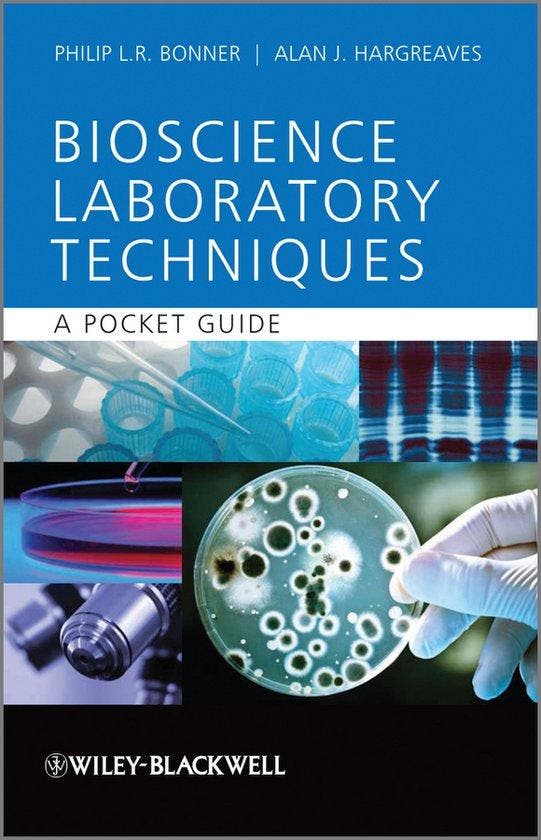
Basic Bioscience Laboratory Techniques 9780470743096, Boeken, Taal | Engels, Gelezen, Verzenden

Kenmerken
Auteur
Philip L.R. Bonner
Conditie
Gelezen
Productnummer (ISBN)
9780470743096
Jaar (oorspr.)
2011
Beschrijving
BoekenBalie maakt van tweedehands jouw eerste keuze. Met een Trustscore van 4,8 (excellent) en 30 dagen retour garantie maken we dat iedere dag waar.
Bestel direct op onze website!
Titel: Basic Bioscience Laboratory Techniques
Auteur: Philip L.R. Bonner
ISBN: 9780470743096
Conditie: Beetje gebruikt
This unique, practical, pocket-sized guide and reference provides every first year bioscience student with all they need to know to prepare reagents correctly and perform fundamental laboratory techniques.
Presented in a user-friendly format, Basic Bioscience Laboratory Techniques is a pocket-sized guide full of tips and advice on everything first year bioscience students need to know to achieve practical success in the laboratory. From how to prepare reagents and master techniques to analyzing data through worked examples and presenting finding, this guide is comprehensive and accessible for when it is needed most; at the bench. This guide:
This unique, practical, pocket-sized guide and reference provides every first year bioscience student with all they need to know to prepare reagents correctly and perform fundamental laboratory techniques. It also helps them to analyse their data and present their findings, in addition to directing the reader, via a comprehensive list of references, to relevant further reading All of the core bioscience laboratory techniques are covered including: basic calculations and the preparation of solutions; aseptic techniques; microscopy techniques; cell fractionation ; spectrophotometry; chromatography of small and large molecules: electrophoresis of proteins and nucleic acids and data analysis. In addition the book includes clear, relevant diagrams and worked examples of calculations. In short, this is a 'must-have' for all first year bioscience students struggling to get to grips with this vitally important element of their course.
Bestel direct op onze website!
Titel: Basic Bioscience Laboratory Techniques
Auteur: Philip L.R. Bonner
ISBN: 9780470743096
Conditie: Beetje gebruikt
This unique, practical, pocket-sized guide and reference provides every first year bioscience student with all they need to know to prepare reagents correctly and perform fundamental laboratory techniques.
Presented in a user-friendly format, Basic Bioscience Laboratory Techniques is a pocket-sized guide full of tips and advice on everything first year bioscience students need to know to achieve practical success in the laboratory. From how to prepare reagents and master techniques to analyzing data through worked examples and presenting finding, this guide is comprehensive and accessible for when it is needed most; at the bench. This guide:
- Covers the core basic bioscience techniques
- Is clearly presented with numerous diagrams and worked examples
- Includes a glossary and suggestions for further reading
- Is linked to a companion website containing additional learning material
This unique, practical, pocket-sized guide and reference provides every first year bioscience student with all they need to know to prepare reagents correctly and perform fundamental laboratory techniques. It also helps them to analyse their data and present their findings, in addition to directing the reader, via a comprehensive list of references, to relevant further reading All of the core bioscience laboratory techniques are covered including: basic calculations and the preparation of solutions; aseptic techniques; microscopy techniques; cell fractionation ; spectrophotometry; chromatography of small and large molecules: electrophoresis of proteins and nucleic acids and data analysis. In addition the book includes clear, relevant diagrams and worked examples of calculations. In short, this is a 'must-have' for all first year bioscience students struggling to get to grips with this vitally important element of their course.
Waarom je bij BoekenBalie moet zijn voor al je tweedehands boeken:
- Bestel je voor 15:00 uur? Dan vliegt het dezelfde dag nog jouw kant op!
- Meer dan 400.000 tweedehands boeken om uit te kiezen
- We checken alle boeken eigenhandig
- Vanaf 40 euro of bij 4 boeken is de verzending op onze rekening
- 30 dagen retourgarantie
Website
boekenbalie.be...
...
...
...
...
...
...
...
...
...
...
...
Bezorgt in heel België
0x bekeken
0x bewaard
Sinds 25 mar '26
Zoekertjesnummer: a160746309
Populaire zoektermen
harry potter engelstaal laten groeienassimil engelsleo engelsharry potter engelsengels lerendisney engels lerenthe hunger games engelstwilight engelsatlas van de nederlandse taalharry potter boeken engelsstephen king engelsengels wielbasic chemistry750 euro in Bestelwagens en Lichte vrachtmercedes e220 amg in Mercedes-Benzelektrische zaag in Gereedschap | Zaagmachinesbrandhout ieper in Brandhoutkvc westerlo in Voetbaloude kloostertafel in Tafels | Eettafelscube attain race in Fietsen | Racefietsenzuigflessen in Babyvoeding en Toebehorenralph lauren jas heren in Jassen | Winterdik touw in IJzerwaren en Bevestigingsmiddelen